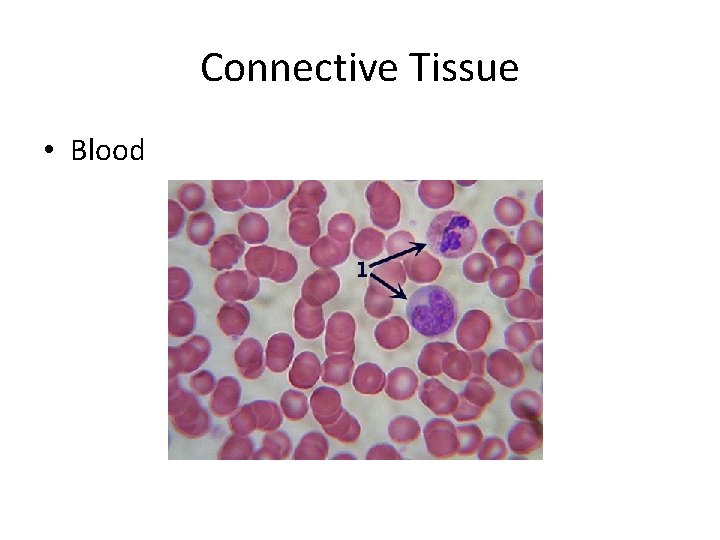
Connective Tissue • Blood
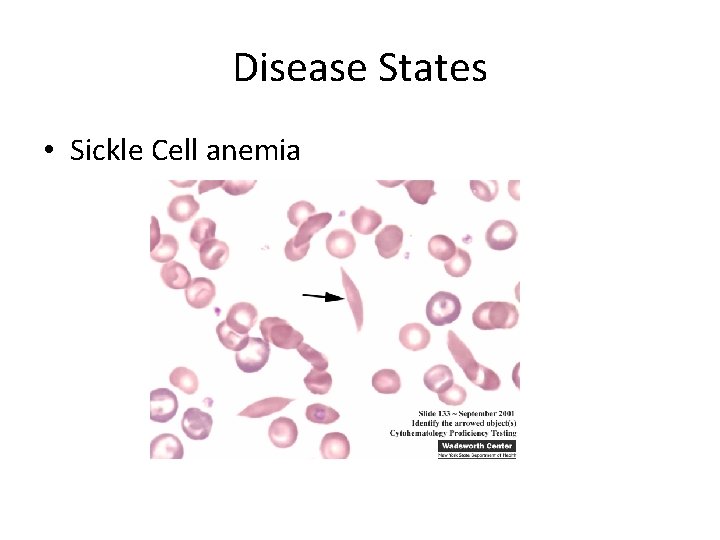
Disease States • Sickle Cell anemia

Cell Journal By AJ Warzecha Epithelial Tissue Simple

Cell Journal By: AJ Warzecha

Epithelial Tissue • Simple Squamous

Epithelial Tissue • Simple Cuboidal

Epithelial Tissue • Simple Columnar

Epithelial Tissue • Startified Squamous Epithelium

Epithelial Tissue • Pseudostratified Epithelium

Epithelial Tissue • Primary function of Epithelium 5 Major functions protection, secretion, absorption, filtration, and excretion. Also helps in transport, sensory reception, and repdroduction

Muscle • Skeletal Muscle

Muscle • Cardiac Muscle

Muscle • Smooth Muscle

Muscle • Primary function of Muscle: Allows movement and maintains body posture. They contain sensory receptors that monitor tension and length of the muscles and give the nervous system information about the location of the body to keep position.

Connective Tissue • Loose Connective tissue

• Dense Connective tissue

Connective Tissue • Adipose Tissue

Connective Tissue • Cartilage

Connective Tissue • Bone
Connective Tissue • Blood

Connective Tissue • Primary Functions of Connective Tissue: Provides structural support for the tissues and organs of the body. It is very important for maintaining the form of the body organs, and tissues. It also serves a nutritive role because all the metabolites from the blood pass from capillary beds and diffuse through connective tissue before returning to the blood capillaries. Some connective tissues play roles in the defense and protection of the body in the vascular/immune system.

Neural Tissue • Neuron

Neural Tissue • Primary Function of neural tissue: Acting as sensory input, incorporation, and organization of muscle/glands, homeostasis, and mental activities. All living cells have capability to react to stimuli and nervous tissue is made up of nervous cells(neurons).
Disease States • Sickle Cell anemia

Disease States • Cancer

Disease States • Tuberculosis

Disease States • Atherosclerosis
- Slides: 24